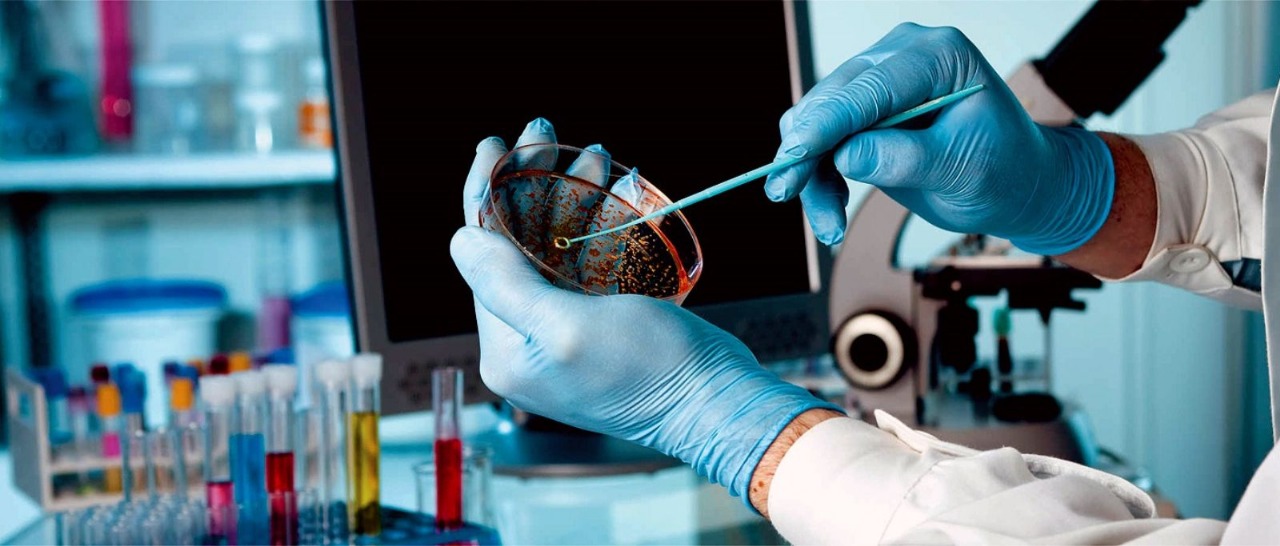
Healthcare

A Trusted & Quality Health Check-up Center
Your health is our priority. Get accurate results, fast.
View Our Services
Advanced Diagnostic Equipment
State-of-the-art technology for precise diagnostics
View Our Equipment
The GCC Health Test Centre is fully equipped with all modern medical check-up facilities and technologies that are necessary to meet local and international requirements. The center is run by qualified professionals in medicine and pathology.
We are committed to providing the highest standard of diagnostic services with precision, efficiency, and compassion. Our continuous pursuit of excellence has positioned us as one of the best in our area of operations, with a reputation for sustained high quality service.
Contact UsEquipped with digitalized modern quality medical machineries for the best health care.
Center run by qualified professionals in medicine and pathology, ensuring reliable results.
Offering thorough Physical Examination, Evaluation, Strength, and Location assessment.
We offer a wide range of diagnostic and preventive health check-up services.

HIV, Hbs Ag, Anti HCV, TB, Syphilis (TPHA, VDRL), Malaria

Serum Bilirubin, Serum Creatinine, Glucose, Cholesterol, SGPT, SGOT

V.Cholera, Salmonella, Shigella, Giardia, Helminthes, Bilharziasis

Sugar, Albumin, Bilharziasis, Opiate, Cannabis

Accurate Blood Grouping and Rh Factor determination
CHEST X-RAY (PA VIEW), and Ultrasound services

Electrocardiography services for heart health monitoring

Reliable and fast qualitative and quantitative pregnancy testing
GCC Health Test Centre is equipped with digitalized modern quality medical machineries for better health care.






Have Questions? Get in touch with us today!
We are available to answer your queries. Feel free to contact us via phone or email.